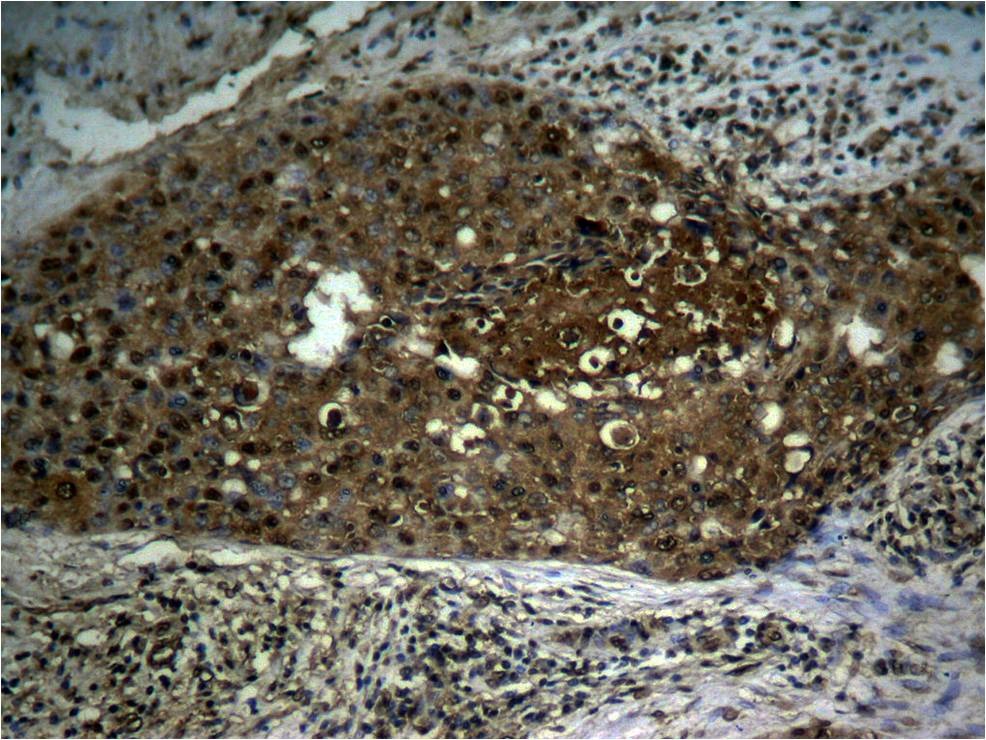

购物车
 您的购物车当前为空
您的购物车当前为空
Anti-Phospho-NF-kB p65 (Ser276) Polyclonal Antibody 是一种 Rabbit 抗体,靶向 Phospho-NF-kB p65 (Ser276)。Anti-Phospho-NF-kB p65 (Ser276) Polyclonal Antibody 可用于 IF,IHC,WB。
别名 v-rel avian reticuloendotheliosis viral oncogene homolog A, p-NF-kB p65 (Ser276), p-NF-kB p65 (S276), p65, NFKB3, NF-kB p65 (p-Ser276), NF-kB p65 (p-S276)
Anti-Phospho-NF-kB p65 (Ser276) Polyclonal Antibody 是一种 Rabbit 抗体,靶向 Phospho-NF-kB p65 (Ser276)。Anti-Phospho-NF-kB p65 (Ser276) Polyclonal Antibody 可用于 IF,IHC,WB。
| 规格 | 价格 | 库存 | 数量 |
|---|---|---|---|
| 50 μL | ¥ 1,490 | 5日内发货 | |
| 100 μL | ¥ 2,230 | 5日内发货 |
TargetMol的所有产品仅用作科学研究或药证申报,不能被用于人体,我们不向个人提供产品和服务。请您遵守承诺用途,不得违反法律法规规定用于任何其他用途。
| 产品描述 | Anti-Phospho-NF-kB p65 (Ser276) Polyclonal Antibody is a Rabbit antibody targeting Phospho-NF-kB p65 (Ser276). Anti-Phospho-NF-kB p65 (Ser276) Polyclonal Antibody can be used in IF,IHC,WB. |
| 别名 | v-rel avian reticuloendotheliosis viral oncogene homolog A, p-NF-kB p65 (Ser276), p-NF-kB p65 (S276), p65, NFKB3, NF-kB p65 (p-Ser276), NF-kB p65 (p-S276) |
| Ig Type | IgG |
| 反应种属 | Human,Mouse,Rat |
| 验证活性 | 1. Immunofluorescence staining of methanol-fixed Hela cells using NFκB-p65 (Phospho-Ser276) Antibody TMAC-02836. 2. Western blot analysis of extract from Hela cells using NF-κB p65 (phospho-Ser276) antibody TMAC-02836. Lane 1: The antibody is not preincubated with blocking peptides. Lane 2: The antibody is preincubated with non-phospho peptide blocking peptides. Lane 3: The antibody is preincubated with phospho peptide blocking peptides. 3. Immunohistochemical analysis of paraffin-embedded human breast carcinoma tissue using NFκB-p65 (Phospho-Ser276) Antibody TMAC-02836 (left) or the same antibody preincubated with blocking peptide (right). 4. Immunohistochemical analysis of paraffin-embedded human breast carcinoma tissue using NFκB-p65 (Phospho-Ser276) antibody TMAC-02836. 5. Immunohistochemical analysis of paraffin-embedded human lung carcinoma tissue using NFκB-p65 (Phospho-Ser276) antibody TMAC-02836. 6. Immunofluorescence staining of methanol-fixed MEF cells untreated or treated with TNF using NFκB-p65 (Phospho-Ser276) Antibody TMAC-02836. |
| 应用 | IFIHCWB |
| 推荐剂量 | WB: 1:500-1000; IF: 1:100-200; IHC: 1:50-100 |
| 抗体种类 | Polyclonal |
| 宿主来源 | Rabbit |
| 构建方式 | Polyclonal Antibody |
| 纯化方式 | Antibodies were produced by immunizing rabbits with synthetic phosphopeptide and KLH conjugates. Antibodies were purified by affinity-chromatography using epitope-specific phosphopeptide. Non-phospho specific antibodies were removed by chromatogramphy using non-phosphopeptide. |
| 性状 | Liquid |
| 缓冲液 | Supplied at 1.0mg/mL in phosphate buffered saline (without Mg2+ and Ca2+), pH 7.4, 150mM NaCl, 0.02% sodium azide and 50% glycerol. |
| 研究背景 | NF-kappa-B is a pleiotropic transcription factor present in almost all cell types and is the endpoint of a series of signal transduction events that are initiated by a vast array of stimuli related to many biological processes such as inflammation, immunity, differentiation, cell growth, tumorigenesis and apoptosis. NF-kappa-B is a homo- or heterodimeric complex formed by the Rel-like domain-containing proteins RELA/p65, RELB, NFKB1/p105, NFKB1/p50, REL and NFKB2/p52 and the heterodimeric p65-p50 complex appears to be most abundant one. The dimers bind at kappa-B sites in the DNA of their target genes and the individual dimers have distinct preferences for different kappa-B sites that they can bind with distinguishable affinity and specificity. Different dimer combinations act as transcriptional activators or repressors, respectively. NF-kappa-B is controlled by various mechanisms of post-translational modification and subcellular compartmentalization as well as by interactions with other cofactors or corepressors. NF-kappa-B complexes are held in the cytoplasm in an inactive state complexed with members of the NF-kappa-B inhibitor (I-kappa-B) family. In a conventional activation pathway, I-kappa-B is phosphorylated by I-kappa-B kinases (IKKs) in response to different activators, subsequently degraded thus liberating the active NF-kappa-B complex which translocates to the nucleus. NF-kappa-B heterodimeric p65-p50 and p65-c-Rel complexes are transcriptional activators. The NF-kappa-B p65-p65 complex appears to be involved in invasin-mediated activation of IL-8 expression. The inhibitory effect of I-kappa-B upon NF-kappa-B the cytoplasm is exerted primarily through the interaction with p65. p65 shows a weak DNA-binding site which could contribute directly to DNA binding in the NF-kappa-B complex. Associates with chromatin at the NF-kappa-B promoter region via association with DDX1. |
| 偶联 | Unconjugated |
| 其他可选修饰符 | Phospho |
| 免疫原 | Peptide sequence around phosphorylation site of serine 276(R-P-S(p)-D-R) derived from Human NFκB-p65 |
| 抗原种属 | Human |
| Uniprot ID |
| 分子量 | Actual: 65 kDa. |
| 储存方式 | Store at -20°C or -80°C for 12 months. Avoid repeated freeze-thaw cycles. |
| 运输方式 | Shipping with blue ice. |